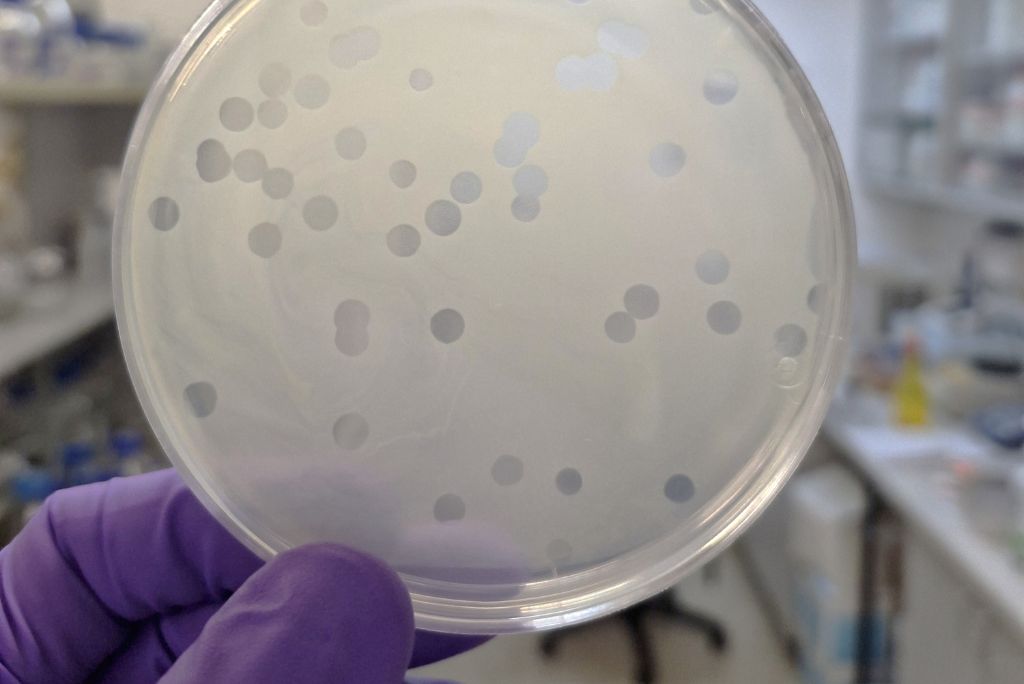
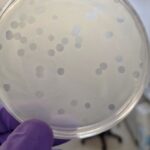

V Virološkem in bakteriološkem laboratoriju se ukvarjamo z raziskavami in diagnostiko rastlinskih bolezni, ki jih povzročajo rastlinski virusi in bakterije. Pomemben del raziskovalnega dela poteka v smeri ekološkega kmetijstva in iskanja alternativnih pristopov pri obvladovanju povzročiteljev bolezni rastlin. Naša ekipa združuje strokovnjake z dolgoletnimi izkušnjami in sodobne analitične metode za identifikacijo in obvladovanje rastlinskih patogenih virusov in bakterij. Delo zajema terenske preglede, laboratorijske analize, pripravo strokovnih poročil in priporočil ter različnih raziskovalnih vsebin. Sodelujemo s kmetijskimi svetovalci, raziskovalnimi ustanovami in drugimi strokovnjaki s področja varstva rastlin in kmetijstva. S svojim delom želimo prispevati k zdravju rastlin ter trajnostnemu kmetijstvu.
Področja dela
Strokovno delo
- Diagnostika rastlinskih virusov in bakterij – poleg klasičnih mikrobioloških metod in serološke metode ELISA izvajamo tudi različne molekularne diagnostične metode (RT-PCR, PCR, qPCR)
- Izvajanje programov uradnega nadzora s poudarkom na Programih preiskav za ugotavljanje navzočnosti povzročiteljev virusnih in bakterijskih bolezni rastlin
- Spremljanje izbranih gospodarsko pomembnih virusov na sadnem drevju, poljščinah, jagodičevju in vinski trti
- Spremljanje izbranih gospodarsko pomembnih bakterij
- Analize virusnih in bakterijskih okužb za potrebe certifikacijskega organa (vinska trta, sadno drevje, krompir)
- Izdelava ocen tveganja
- Svetovanje in izdelava strokovnih mnenj, priporočil
- Vzdrževanje referenčne in delovne zbirke virusov in izbranih bakterij
Raziskovalno delo
- Določanje novih virusov in njihova karakterizacija
- Epidemiologija virusov in viroidov
- Raziskave virusov jagodičevja
- Preučevanje interakcij med virusi in gostiteljskimi rastlinami, vpliv na rastlinsko fiziologijo
- Preučevanje interakcij med virusi in prenašalci (žuželke, ogorčice, glive)
- Ekološko kmetijstvo in preučevanje učinkovitih virusnih biotičnih agensov proti bakterijskim povzročiteljem bolezni rastlin
- Raziskovanje bakteriofagov črne žilavke kapusnic in njihove uporabe kot biokontrolnih agensov
- Sodelovanje pri različnih aktualnih raziskovalnih projektih